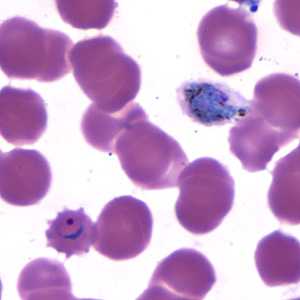
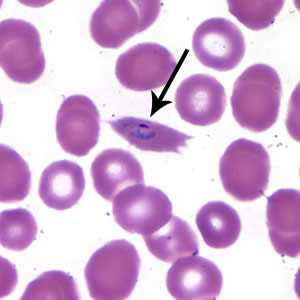
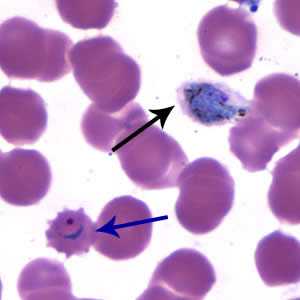

Case #173 - February, 2006
A 29-year-old missionary lived in Gabon and Cameroon for one year. Eight months into her stay, she went to a medical clinic with complaints of headache, fever, chills, and some diarrhea. She reported to the physician that she did not adhere consistently to her malaria prophylaxis regime. The physician ordered a blood film examination; thick and thin blood films were made and stained with Wright’s. Figures A-D show objects that were seen on the thin blood film. What is your diagnosis? Based on what criteria? Would you recommend any laboratory confirmatory test to make the diagnosis specific?

Figure A

Figure B
Figure C

Figure D
Case Answer
This was a case of malaria caused by Plasmodium ovale. Diagnostic features included:
- the presence of fimbriated, infected red blood cells (RBC’s) consistent with P. ovale (Figures A, B, and C, black arrows). It is important to differentiate fimbriation from crenation. Fimbriation is a diagnostic feature of RBC’s infected by P. ovale, while crenation is not. Figure C shows a ring stage parasite in a crenated RBC (blue arrow).
- the presence of gametocytes in slightly enlarged, oval-shaped RBC’s (Figure C, black arrow).
- sturdy ring-form stage parasites (Figures A and C).
- an immature schizont in a slightly enlarged RBC (Figure D).

Figure A
Figure B
Figure C
Because of the clear morphologic features observed, additional confirmatory testing such as PCR was not deemed necessary in this case.
More on: Malaria
Images presented in the monthly case studies are from specimens submitted for diagnosis or archiving. On rare occasions, clinical histories given may be partly fictitious.
DPDx is an education resource designed for health professionals and laboratory scientists. For an overview including prevention and control visit www.cdc.gov/parasites/.
- Page last reviewed: August 24, 2016
- Page last updated: August 24, 2016
- Content source:
- Global Health – Division of Parasitic Diseases and Malaria
- Notice: Linking to a non-federal site does not constitute an endorsement by HHS, CDC or any of its employees of the sponsors or the information and products presented on the site.
- Maintained By:


 ShareCompartir
ShareCompartir